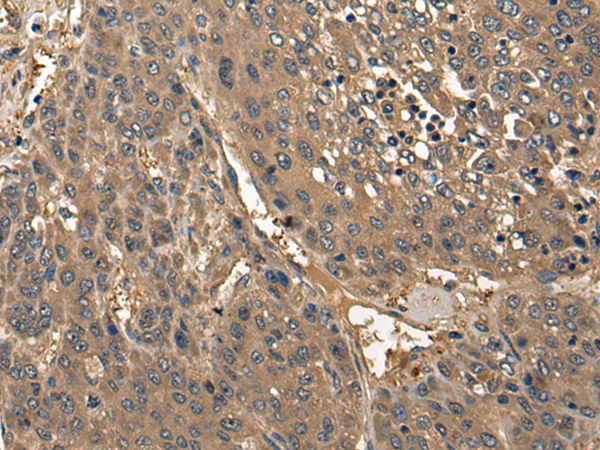

|
Background: |
This gene encodes a brain-specific membrane associated collagen. A product of proteolytic processing of the encoded protein, CLAC (collagenous Alzheimer amyloid plaque component), binds to amyloid beta-peptides found in Alzheimer amyloid plaques but CLAC inhibits rather than facilitates amyloid fibril elongation (PMID: 16300410). A study of over-expression of this collagen in mice, however, found changes in pathology and behavior suggesting that the encoded protein may promote amyloid plaque formation (PMID: 19548013). Multiple transcript variants encoding different isoforms have been found for this gene. |
|
Applications: |
ELISA, WB, IHC |
|
Name of antibody: |
COL25A1 |
|
Immunogen: |
Synthetic peptide of human COL25A1 |
|
Full name: |
collagen type XXV alpha 1 |
|
Synonyms: |
AMY; CLAC; CLACP; CFEOM5; CLAC-P |
|
SwissProt: |
Q9BXS0 |
|
ELISA Recommended dilution: |
5000-10000 |
|
WB Predicted band size: |
65 kDa |
|
WB Positive control: |
A549,Jurkat and A172 cell,Human testis tissue,Hela cell lysates |
|
WB Recommended dilution: |
200-1000 |
購(gòu)物車
幫助
021-54845833/15800441009
